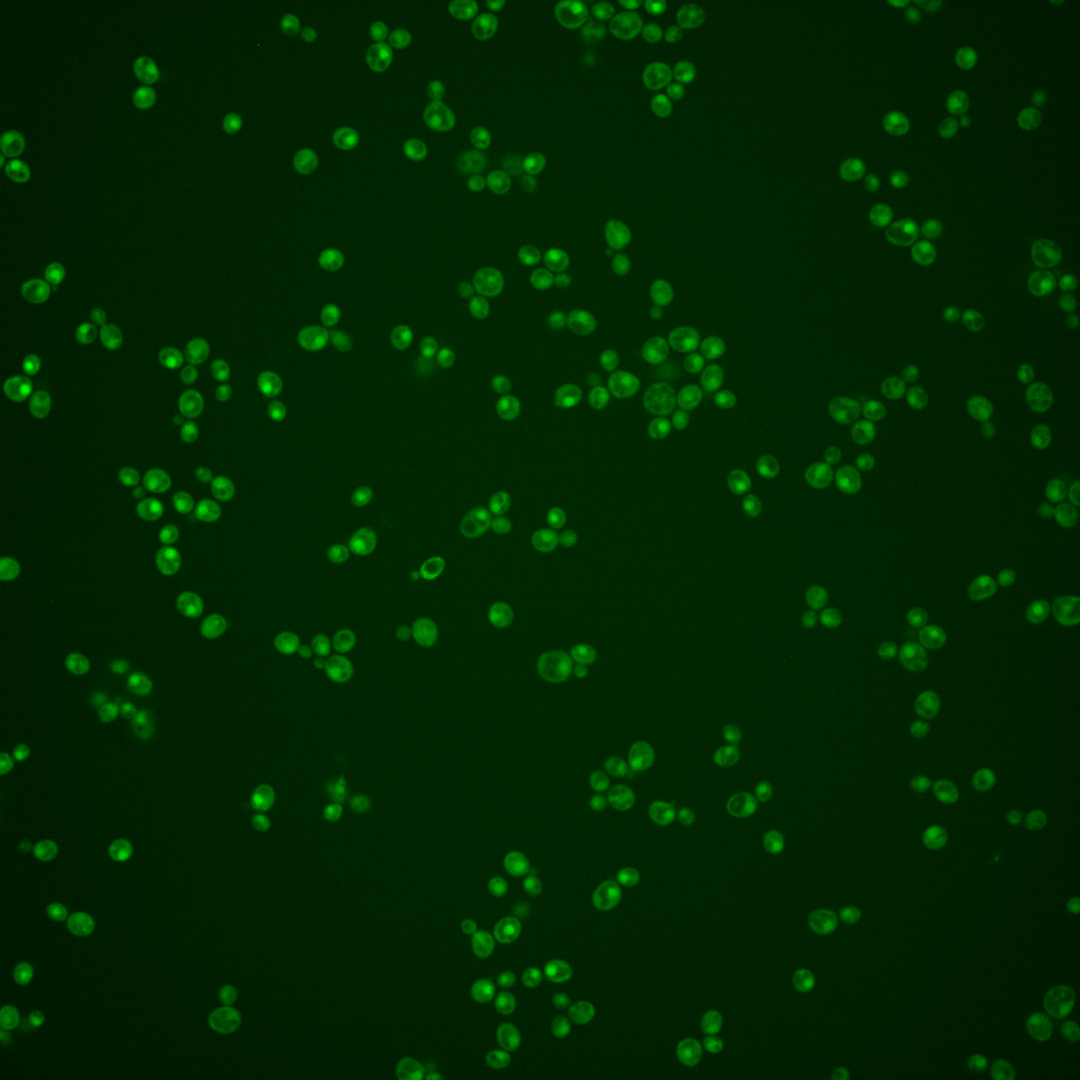
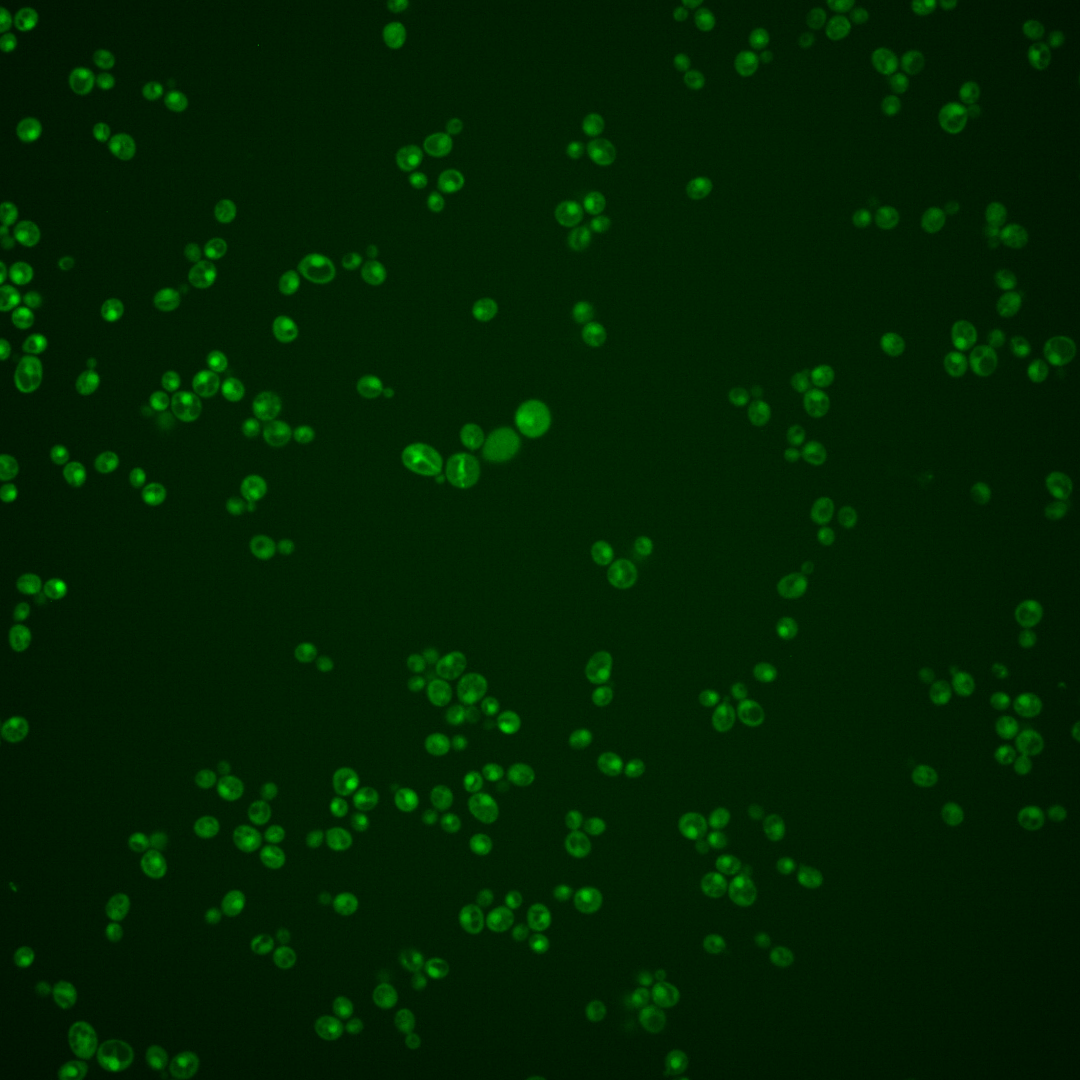
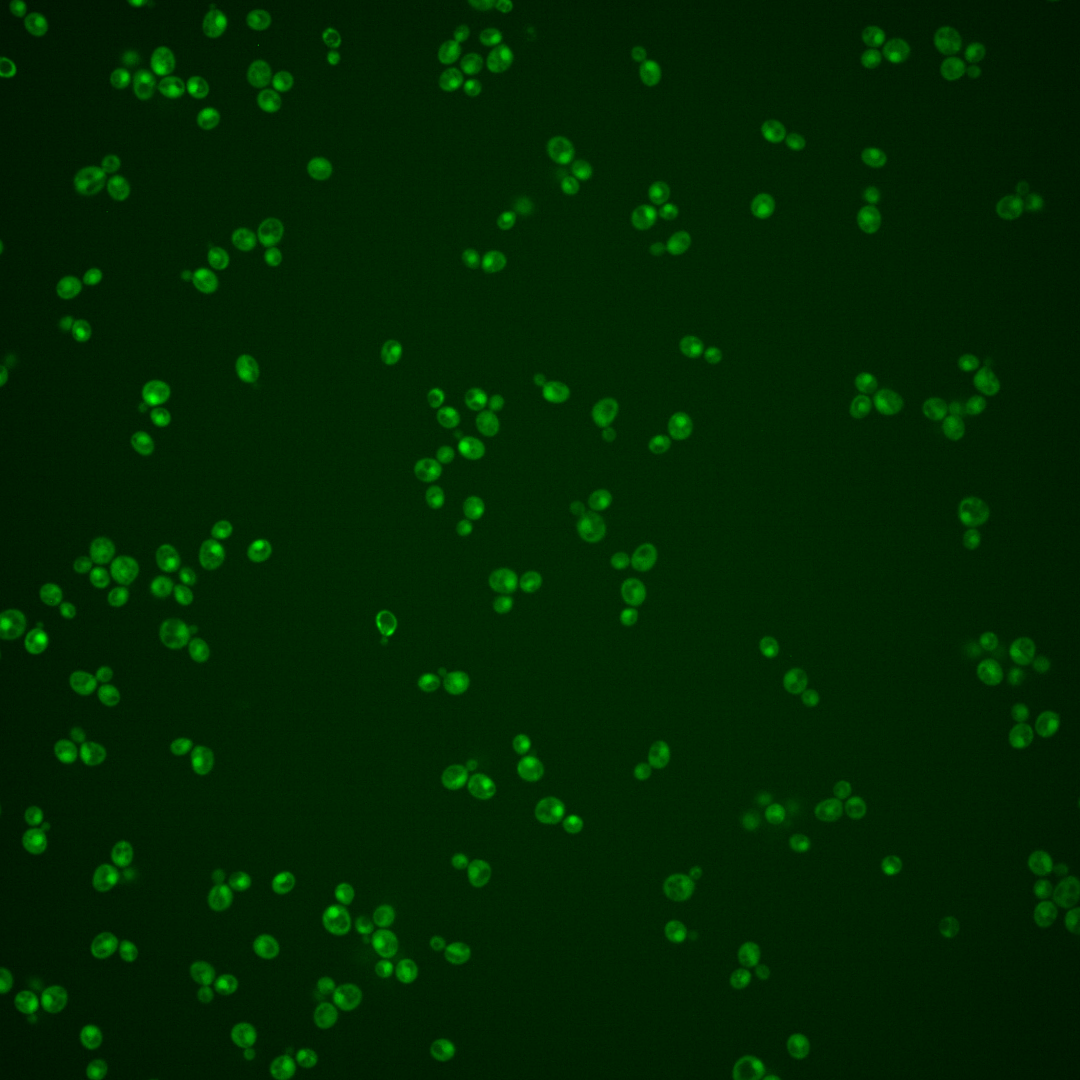
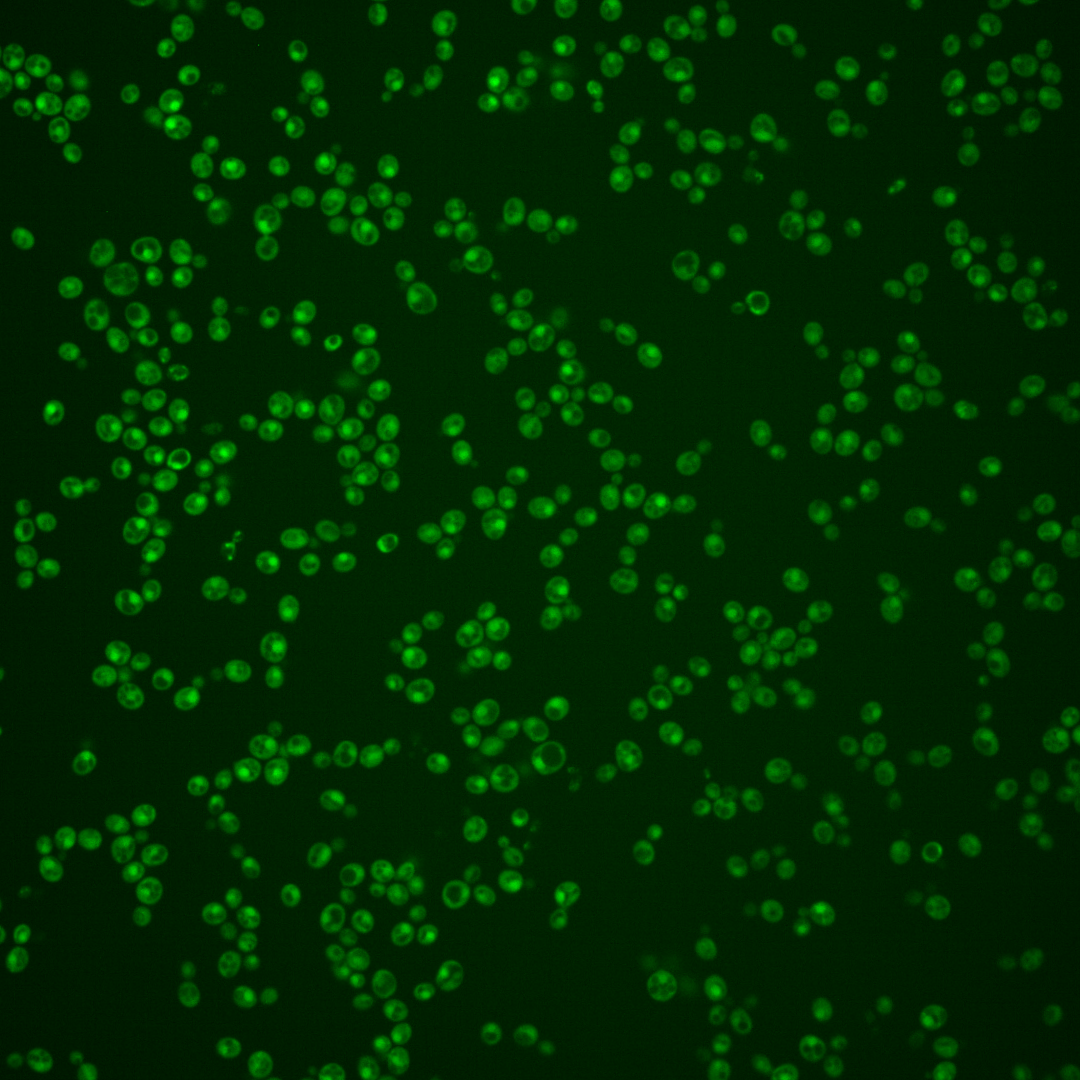
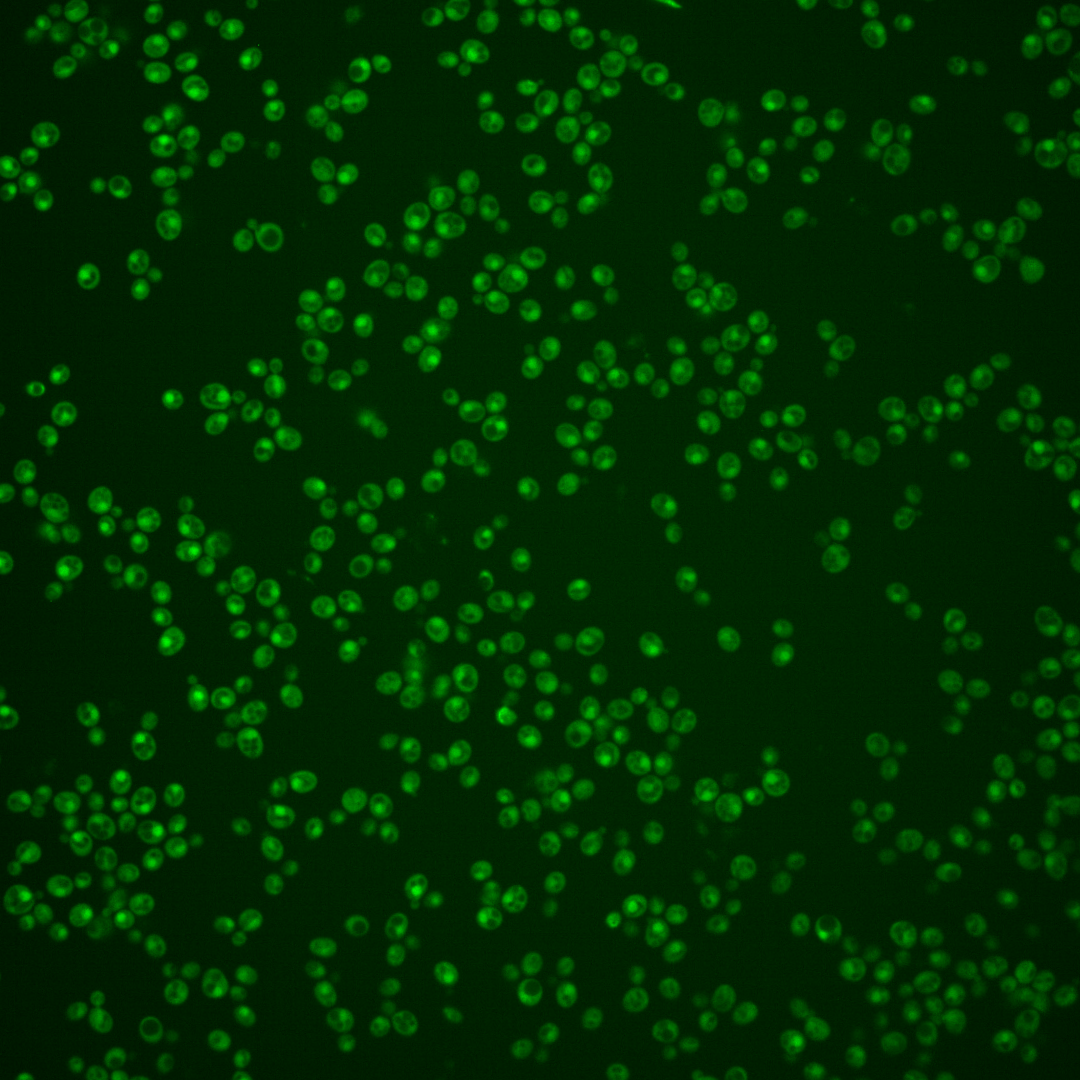
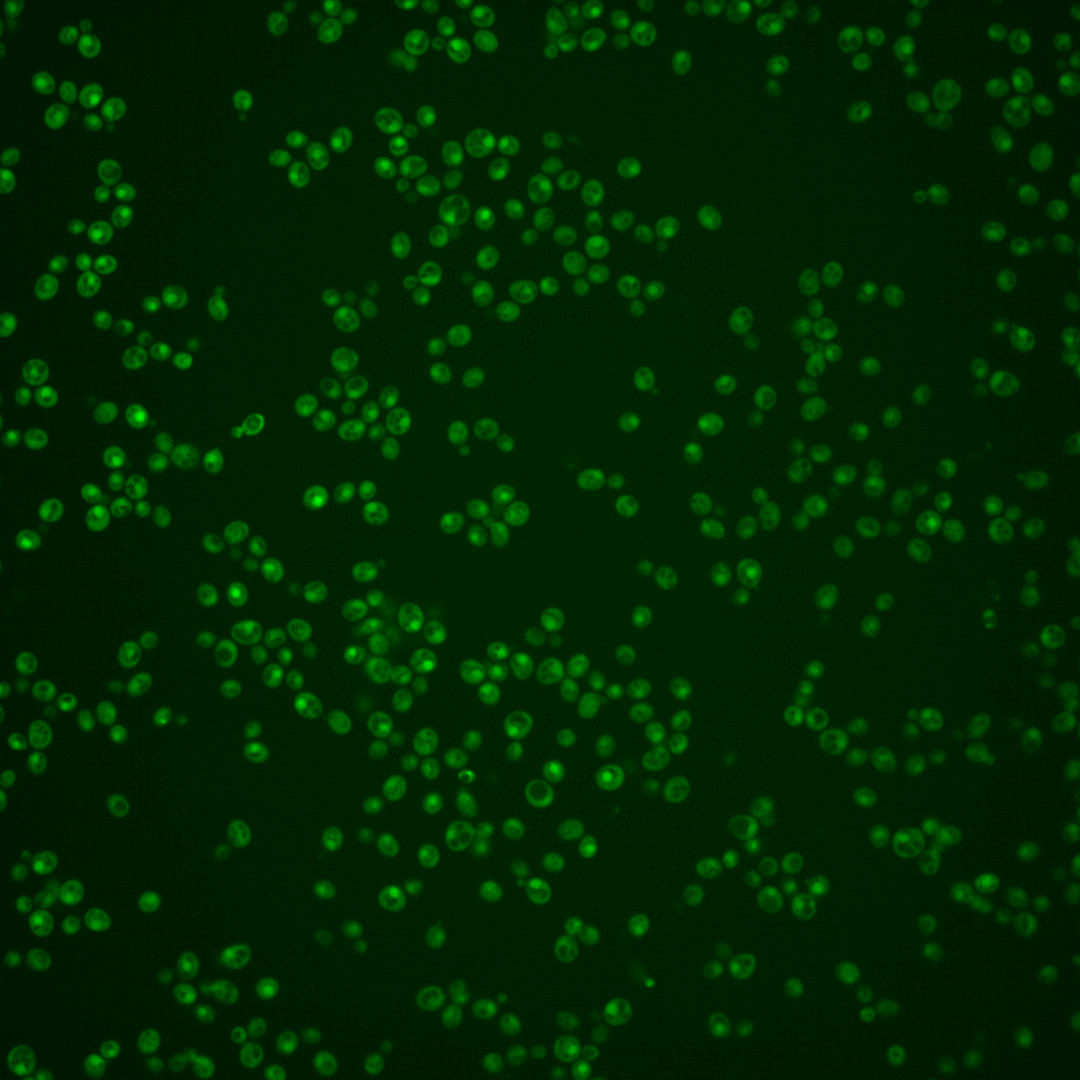

| ORF | |
|---|---|
| Human Ortholog | |
| Description | Protein of unknown function; green fluorescent protein (GFP)-fusion protein localizes to the cytoplasm and the nucleus; relocalizes from nucleus to cytoplasm upon DNA replication stress; YOR342C has a paralog, YAL037W, that arose from the whole genome duplication |
Micrographs




















































































Sub-cellular Localization
Yeast GFP Assignment
Protein Abundance
Localization Change
External localization resources
| ensLOC | DeepLoc | |||||||||||||||||||||||
|---|---|---|---|---|---|---|---|---|---|---|---|---|---|---|---|---|---|---|---|---|---|---|---|---|
| Localization | WT1 | WT2 | WT3 | RAP60 | RAP140 | RAP220 | RAP300 | RAP380 | RAP460 | RAP540 | RAP620 | RAP700 | HU80 | HU120 | HU160 | rpd3Δ_1 | rpd3Δ_2 | rpd3Δ_3 | WT1 | WT2 | WT3 | AF100 | AF140 | AF180 |
| Cortical Patches | 0 | 0 | 1 | 0 | 0 | 0 | 0 | 0 | 0 | 0 | 0 | 0 | 0 | 1 | 0 | 0 | 0 | 0 | 0 | 1 | 0 | 2 | 4 | 10 |
| Bud | 0 | 0 | 0 | 0 | 0 | 3 | 5 | 2 | 10 | 7 | 3 | 3 | 0 | 0 | 0 | 0 | 0 | 0 | 5 | 8 | 4 | 2 | 10 | 14 |
| Bud Neck | 0 | 0 | 2 | 1 | 2 | 2 | 5 | 8 | 3 | 8 | 3 | 12 | 0 | 0 | 1 | 0 | 0 | 0 | 0 | 1 | 1 | 1 | 1 | 3 |
| Bud Site | 0 | 0 | 0 | 0 | 0 | 0 | 1 | 0 | 0 | 0 | 0 | 1 | 0 | 0 | 0 | 0 | 0 | 0 | – | – | – | – | – | – |
| Cell Periphery | 0 | 0 | 0 | 0 | 3 | 1 | 0 | 1 | 0 | 1 | 0 | 0 | 0 | 1 | 0 | 0 | 0 | 1 | 0 | 0 | 0 | 0 | 1 | 2 |
| Cytoplasm | 14 | 50 | 72 | 81 | 334 | 263 | 333 | 373 | 188 | 258 | 153 | 191 | 164 | 412 | 457 | 79 | 78 | 66 | 17 | 24 | 59 | 243 | 343 | 342 |
| Endoplasmic Reticulum | 0 | 2 | 0 | 0 | 1 | 1 | 0 | 0 | 0 | 1 | 0 | 1 | 1 | 1 | 1 | 4 | 10 | 8 | 0 | 0 | 1 | 0 | 3 | 1 |
| Endosome | 0 | 1 | 1 | 2 | 2 | 2 | 1 | 1 | 0 | 0 | 0 | 0 | 7 | 1 | 2 | 16 | 16 | 14 | 1 | 4 | 3 | 5 | 4 | 5 |
| Golgi | 0 | 0 | 0 | 0 | 1 | 0 | 0 | 0 | 0 | 0 | 0 | 0 | 1 | 0 | 0 | 0 | 1 | 0 | 1 | 0 | 0 | 1 | 0 | 1 |
| Mitochondria | 26 | 5 | 0 | 18 | 8 | 61 | 137 | 101 | 114 | 124 | 117 | 109 | 0 | 0 | 1 | 0 | 1 | 2 | 0 | 4 | 3 | 5 | 9 | 12 |
| Nucleus | 42 | 80 | 112 | 73 | 2 | 5 | 3 | 9 | 4 | 9 | 4 | 2 | 37 | 5 | 1 | 13 | 18 | 10 | 86 | 140 | 125 | 3 | 0 | 0 |
| Nuclear Periphery | 0 | 0 | 0 | 0 | 0 | 0 | 0 | 0 | 0 | 0 | 0 | 0 | 0 | 0 | 0 | 0 | 0 | 0 | 0 | 0 | 1 | 0 | 0 | 0 |
| Nucleolus | 0 | 0 | 0 | 0 | 1 | 0 | 1 | 1 | 2 | 0 | 0 | 1 | 0 | 1 | 0 | 1 | 1 | 1 | 0 | 1 | 0 | 0 | 0 | 0 |
| Peroxisomes | 0 | 0 | 0 | 0 | 0 | 0 | 0 | 0 | 0 | 0 | 0 | 0 | 0 | 0 | 0 | 0 | 0 | 0 | 0 | 0 | 0 | 0 | 0 | 0 |
| SpindlePole | 0 | 0 | 0 | 0 | 0 | 0 | 1 | 3 | 3 | 2 | 2 | 9 | 1 | 0 | 0 | 4 | 5 | 3 | 2 | 6 | 10 | 3 | 8 | 10 |
| Vac/Vac Membrane | 57 | 121 | 53 | 53 | 17 | 20 | 6 | 10 | 1 | 12 | 3 | 8 | 64 | 35 | 15 | 70 | 68 | 68 | 14 | 27 | 36 | 6 | 3 | 4 |
| Unique Cell Count | 114 | 201 | 215 | 201 | 352 | 308 | 413 | 449 | 257 | 356 | 239 | 280 | 239 | 437 | 465 | 149 | 163 | 144 | 131 | 224 | 251 | 284 | 399 | 417 |
| Labelled Cell Count | 139 | 259 | 241 | 228 | 371 | 358 | 493 | 509 | 325 | 422 | 285 | 337 | 275 | 457 | 478 | 187 | 198 | 173 | 131 | 224 | 251 | 284 | 399 | 417 |
Yeast GFP Assignment
Protein Abundance
| Screen | WT1 | WT2 | WT3 | RAP60 | RAP140 | RAP220 | RAP300 | RAP380 | RAP460 | RAP540 | RAP620 | RAP700 | HU80 | HU120 | HU160 | rpd3Δ_1 | rpd3Δ_2 | rpd3Δ_3 | AF100 | AF140 | AF180 |
|---|---|---|---|---|---|---|---|---|---|---|---|---|---|---|---|---|---|---|---|---|---|
| Mean Cell GFP Intensity (1e-4) | 4.8 | 7.2 | 6.3 | 5.4 | 4.9 | 3.9 | 3.4 | 4.1 | 3.3 | 3.4 | 3.2 | 3.4 | 6.1 | 5.8 | 5.6 | 8.2 | 7.9 | 7.5 | 5.4 | 5.3 | 5.7 |
| Std Deviation (1e-4) | 0.9 | 1.2 | 1.1 | 1.3 | 1.3 | 1.3 | 1.0 | 1.3 | 1.5 | 1.2 | 1.6 | 1.1 | 1.1 | 1.0 | 1.2 | 1.7 | 2.0 | 1.8 | 1.6 | 1.3 | 1.5 |
| Intensity Change (Log2) | – | – | – | -0.2 | -0.36 | -0.68 | -0.86 | -0.62 | -0.9 | -0.87 | -0.96 | -0.88 | -0.03 | -0.11 | -0.16 | 0.4 | 0.34 | 0.26 | -0.22 | -0.24 | -0.14 |
Localization Change
| Localization | RAP60 | RAP140 | RAP220 | RAP300 | RAP380 | RAP460 | RAP540 | RAP620 | RAP700 | HU80 | HU120 | HU160 | rpd3Δ_1 | rpd3Δ_2 | rpd3Δ_3 |
|---|---|---|---|---|---|---|---|---|---|---|---|---|---|---|---|
| Cortical Patches | 0 | 0 | 0 | 0 | 0 | 0 | 0 | 0 | 0 | 0 | 0 | 0 | 0 | 0 | 0 |
| Bud | 0 | 0 | 0 | 0 | 0 | 0 | 0 | 0 | 0 | 0 | 0 | 0 | 0 | 0 | 0 |
| Bud Neck | 0 | 0 | 0 | 0 | 0 | 0 | 0 | 0 | 0 | 0 | 0 | 0 | 0 | 0 | 0 |
| Bud Site | 0 | 0 | 0 | 0 | 0 | 0 | 0 | 0 | 0 | 0 | 0 | 0 | 0 | 0 | 0 |
| Cell Periphery | 0 | 0 | 0 | 0 | 0 | 0 | 0 | 0 | 0 | 0 | 0 | 0 | 0 | 0 | 0 |
| Cytoplasm | 1.4 | 15.7 | 12.2 | 11.7 | 12.7 | 8.6 | 9.1 | 6.5 | 7.7 | 7.5 | 16.7 | 18.9 | 3.7 | 2.8 | 2.4 |
| Endoplasmic Reticulum | 0 | 0 | 0 | 0 | 0 | 0 | 0 | 0 | 0 | 0 | 0 | 0 | 0 | 0 | 0 |
| Endosome | 0 | 0 | 0 | 0 | 0 | 0 | 0 | 0 | 0 | 0 | 0 | 0 | 4.6 | 4.3 | 4.3 |
| Golgi | 0 | 0 | 0 | 0 | 0 | 0 | 0 | 0 | 0 | 0 | 0 | 0 | 0 | 0 | 0 |
| Mitochondria | 4.5 | 0 | 0 | 0 | 0 | 0 | 0 | 0 | 0 | 0 | 0 | 0 | 0 | 0 | 0 |
| Nucleus | -3.2 | -14.9 | -13.6 | -15.8 | -15.6 | -12.7 | -14.0 | -12.3 | -13.5 | -8.3 | -15.9 | -16.9 | -8.6 | -8.3 | -8.9 |
| Nuclear Periphery | 0 | 0 | 0 | 0 | 0 | 0 | 0 | 0 | 0 | 0 | 0 | 0 | 0 | 0 | 0 |
| Nucleolus | 0 | 0 | 0 | 0 | 0 | 0 | 0 | 0 | 0 | 0 | 0 | 0 | 0 | 0 | 0 |
| Peroxisomes | 0 | 0 | 0 | 0 | 0 | 0 | 0 | 0 | 0 | 0 | 0 | 0 | 0 | 0 | 0 |
| SpindlePole | 0 | 0 | 0 | 0 | 0 | 0 | 0 | 0 | 0 | 0 | 0 | 0 | 0 | 0 | 0 |
| Vacuole | 0.4 | -7.0 | -5.9 | -9.5 | -9.2 | -8.2 | -7.8 | -7.6 | -7.3 | 0.5 | -5.8 | -8.7 | 4.4 | 3.5 | 4.4 |
External localization resources
Images






























Protein Concentration and Protein Localization Data
| R1 | R2 | R3 | ||||||||||||||||
|---|---|---|---|---|---|---|---|---|---|---|---|---|---|---|---|---|---|---|
| G1 Pre-START | G1 Post-START | S/G2 | Metaphase | Anaphase | Telophase | G1 Pre-START | G1 Post-START | S/G2 | Metaphase | Anaphase | Telophase | G1 Pre-START | G1 Post-START | S/G2 | Metaphase | Anaphase | Telophase | |
| Concentration | 1.6414 | 1.3852 | 1.1765 | 0.8555 | 0.4969 | 1.1266 | 1.9181 | 2.3013 | 1.8654 | 1.0068 | 0.7128 | 1.6782 | 2.094 | 2.4998 | 2.2905 | 1.7598 | 1.415 | 2.0435 |
| Actin | 0.0402 | 0.0003 | 0.0153 | 0.0016 | 0.0191 | 0.0032 | 0.0127 | 0.0001 | 0.0146 | 0.0002 | 0.0004 | 0.0021 | 0.0001 | 0.0001 | 0.0003 | 0.0003 | 0.0004 | 0.0002 |
| Bud | 0.0012 | 0.0024 | 0.0006 | 0.0004 | 0.0008 | 0.0013 | 0.0033 | 0.0003 | 0.0008 | 0.0002 | 0.0002 | 0.0047 | 0.0005 | 0.0001 | 0.0012 | 0.0008 | 0.0007 | 0.001 |
| Bud Neck | 0.0033 | 0.0006 | 0.0016 | 0.001 | 0.0044 | 0.0049 | 0.0071 | 0.0005 | 0.0007 | 0.0011 | 0.0021 | 0.0026 | 0.0004 | 0.0004 | 0.0004 | 0.0008 | 0.0015 | 0.0023 |
| Bud Periphery | 0.0015 | 0.0006 | 0.0005 | 0.0003 | 0.0011 | 0.0015 | 0.0007 | 0.0001 | 0.0019 | 0.0002 | 0.0001 | 0.0008 | 0.0005 | 0 | 0.0002 | 0.0002 | 0.0003 | 0.0003 |
| Bud Site | 0.0026 | 0.0025 | 0.0017 | 0.001 | 0.0016 | 0.0004 | 0.0043 | 0.0018 | 0.0013 | 0.0002 | 0.0003 | 0.0002 | 0.0005 | 0.0004 | 0.0008 | 0.0003 | 0.0009 | 0.0003 |
| Cell Periphery | 0.0002 | 0 | 0.0001 | 0 | 0.0001 | 0.0001 | 0.0001 | 0 | 0.0001 | 0 | 0 | 0 | 0 | 0 | 0.0001 | 0 | 0 | 0 |
| Cytoplasm | 0.138 | 0.2711 | 0.1307 | 0.1984 | 0.2598 | 0.1458 | 0.113 | 0.2188 | 0.1064 | 0.1484 | 0.1622 | 0.1086 | 0.1152 | 0.1891 | 0.1312 | 0.2003 | 0.2324 | 0.1282 |
| Cytoplasmic Foci | 0.0246 | 0.0023 | 0.0071 | 0.016 | 0.0142 | 0.007 | 0.0114 | 0.0018 | 0.0076 | 0.0006 | 0.0017 | 0.003 | 0.0043 | 0.0011 | 0.003 | 0.0027 | 0.0047 | 0.0063 |
| Eisosomes | 0.0002 | 0 | 0.0002 | 0 | 0.0002 | 0.0001 | 0.0002 | 0 | 0.0001 | 0 | 0 | 0 | 0 | 0 | 0 | 0 | 0 | 0 |
| Endoplasmic Reticulum | 0.0058 | 0.0027 | 0.0027 | 0.0062 | 0.0084 | 0.0025 | 0.0065 | 0.0034 | 0.0018 | 0.0014 | 0.0162 | 0.0014 | 0.0022 | 0.0031 | 0.0023 | 0.0034 | 0.0026 | 0.0014 |
| Endosome | 0.0421 | 0.003 | 0.0207 | 0.0421 | 0.0339 | 0.011 | 0.0263 | 0.0023 | 0.0074 | 0.0012 | 0.0081 | 0.0041 | 0.003 | 0.0026 | 0.0038 | 0.0078 | 0.0069 | 0.0032 |
| Golgi | 0.0131 | 0.0001 | 0.0088 | 0.0027 | 0.0057 | 0.0027 | 0.0031 | 0 | 0.0022 | 0 | 0.0001 | 0.0006 | 0.0001 | 0 | 0.0001 | 0.0001 | 0.0002 | 0.0001 |
| Lipid Particles | 0.0208 | 0.0001 | 0.0065 | 0.0084 | 0.005 | 0.0064 | 0.0043 | 0.0001 | 0.0039 | 0 | 0.0002 | 0.0017 | 0.0002 | 0.0001 | 0.0003 | 0.0001 | 0.0001 | 0.0002 |
| Mitochondria | 0.0102 | 0.0005 | 0.011 | 0.0029 | 0.0033 | 0.0037 | 0.0017 | 0.0004 | 0.0144 | 0.0004 | 0.0019 | 0.001 | 0.0015 | 0.0003 | 0.0018 | 0.0004 | 0.0007 | 0.0003 |
| None | 0.0496 | 0.045 | 0.0551 | 0.1094 | 0.1439 | 0.0562 | 0.0266 | 0.0613 | 0.06 | 0.0022 | 0.0134 | 0.0196 | 0.0352 | 0.0143 | 0.0214 | 0.0073 | 0.0683 | 0.0144 |
| Nuclear Periphery | 0.0432 | 0.0223 | 0.0184 | 0.0383 | 0.0418 | 0.0181 | 0.027 | 0.0146 | 0.0136 | 0.0159 | 0.0338 | 0.0121 | 0.0135 | 0.0214 | 0.0126 | 0.0185 | 0.0185 | 0.0099 |
| Nucleolus | 0.0027 | 0.0018 | 0.0024 | 0.0019 | 0.0074 | 0.0029 | 0.0048 | 0.0015 | 0.0017 | 0.0015 | 0.0057 | 0.0023 | 0.002 | 0.0012 | 0.0033 | 0.0022 | 0.0023 | 0.0023 |
| Nucleus | 0.5424 | 0.6246 | 0.6721 | 0.5434 | 0.376 | 0.6864 | 0.7103 | 0.68 | 0.7109 | 0.8166 | 0.7267 | 0.8088 | 0.8051 | 0.7539 | 0.7995 | 0.7192 | 0.6288 | 0.7915 |
| Peroxisomes | 0.0161 | 0.0001 | 0.0091 | 0.0027 | 0.0016 | 0.0012 | 0.0025 | 0.0001 | 0.0065 | 0 | 0.0001 | 0.0014 | 0.0003 | 0 | 0.0001 | 0.0001 | 0.0002 | 0.0001 |
| Punctate Nuclear | 0.0261 | 0.0173 | 0.0317 | 0.017 | 0.0652 | 0.0419 | 0.0302 | 0.0108 | 0.0406 | 0.0081 | 0.0237 | 0.024 | 0.0128 | 0.0097 | 0.0161 | 0.0337 | 0.0265 | 0.0367 |
| Vacuole | 0.0112 | 0.0023 | 0.0025 | 0.0046 | 0.0045 | 0.0018 | 0.0029 | 0.0017 | 0.0024 | 0.0015 | 0.0021 | 0.001 | 0.0021 | 0.0016 | 0.0012 | 0.0015 | 0.0035 | 0.0011 |
| Vacuole Periphery | 0.0049 | 0.0005 | 0.001 | 0.0016 | 0.0021 | 0.001 | 0.001 | 0.0003 | 0.0011 | 0.0003 | 0.001 | 0.0004 | 0.0004 | 0.0004 | 0.0003 | 0.0004 | 0.0006 | 0.0002 |
Sequencing Data
| R1 | R2 | |||||||||
|---|---|---|---|---|---|---|---|---|---|---|
| G1 Post-START | S/G2 | Metaphase | Anaphase | Telophase | G1 Post-START | S/G2 | Metaphase | Anaphase | Telophase | |
| Gene Expression | 39.6536 | 13.3572 | 33.547 | 51.0112 | 34.2751 | 17.2311 | 8.0513 | 10.5176 | 19.2154 | 49.0076 |
| Translational Efficiency | 0.5057 | 0.6795 | 0.4746 | 0.4425 | 0.7204 | 1.0447 | 0.582 | 0.2718 | 0.6713 | 0.5781 |
Hit Data
| Dataset | Hit |
|---|---|
| Protein Concentration | ✔ |
| Protein Localization | ✘ |
| Gene Expression | ✔ |
| Translational Efficiency | ✘ |
Endocytosis
| Temp | Actin Patch (Sac6-tdTomato) | Cortical Patch (Sla1-GFP) | Late Endosome (Snf7-GFP) | Vacuole (Vph1-GFP) |
|---|---|---|---|---|
| 37℃ | ||||
| RT |
Cell Cycle Omics
CYCLoPs (Yor342c-GFP)
| Gene / Allele | Actin Patch (Sac6-tdTomato) | Cortical Patch (Sla1-GFP) | Late Endosome (Snf7-GFP) | Vacuole (Sac6-tdTomato) |
|---|
| Gene | Images |
|---|
| Gene | Images |
|---|
Images are not yet available
Images are not yet available